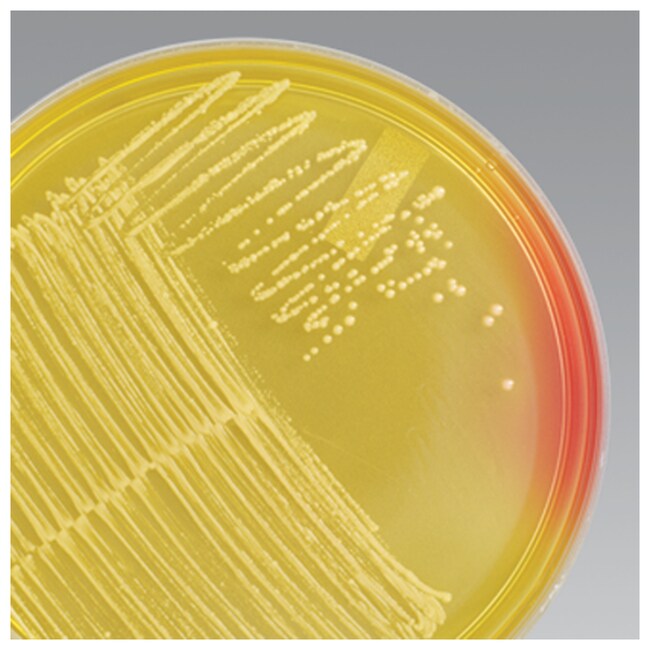

Search
Mannitol Salt Agar (Dehydrated)
Selectively and differentially isolate staphylococci from clinical and non-clinical samples using Mannitol Salt Agar.
| Catalog Number | Quantity |
|---|---|
| R453902 | 500 g |
Selectively and differentially isolate staphylococci using Thermo Scientific™ Remel™ Mannitol Salt Agar (Dehydrated). This phenol red mannitol agar contains 7.5% sodium chloride as a selective agent as reported by Koch in 19421. Most strains of coagulase-positive staphylococci grow on this agar, producing yellow zones because of mannitol fermentation, whereas coagulase-negative staphylococci strains produce small colonies with no color change in the surrounding medium. This agar is formulated in conformance with harmonized United States Pharmacopeia (USP)/European Pharmacopeia (EP) guidelines2,3.
Mannitol Salt Agar is a selective and differential solid media for isolating staphylococci by their ability to ferment mannitol.
- Conforms to USP and EP: Formulated in conformance with harmonized United States Pharmacopeia (USP)/European Pharmacopeia (EP) guidelines2,,3.
- Easy to differentiate: Differentiates between coagulase-positive and coagulase-negative staphylococci on the basis of mannitol fermentation
- Selective: Sodium chloride at a concentration of 7.5% inhibits many bacteria other than staphylococci.
This medium contains casein and meat peptones that supply nitrogen, amino acids, and peptides necessary for bacterial growth. Sodium chloride in the concentration of 7.5% is a selective agent that inhibits many bacteria other than staphylococci. Phenol red is the pH indicator which causes a color change in the medium from red-orange to yellow when acid is produced. Colonies of staphylococci that ferment mannitol will be surrounded by a yellow zone, while those that do not ferment mannitol will have no color change (red).
Not all products are available for sale in all territories. Please inquire.
Remel™ and Oxoid™ products are now part of the Thermo Scientific brand
- Koch, F.D. 1942. Zentr. Bakt. Labt. Orig. 149:122.
- The United States Pharmacopeia. United States Pharmacopeial Convention. Rockville, MD.
- The European Pharmacopoeia. 2002. 4th European Department for the Quality of Medicines, Strasbourg, France.